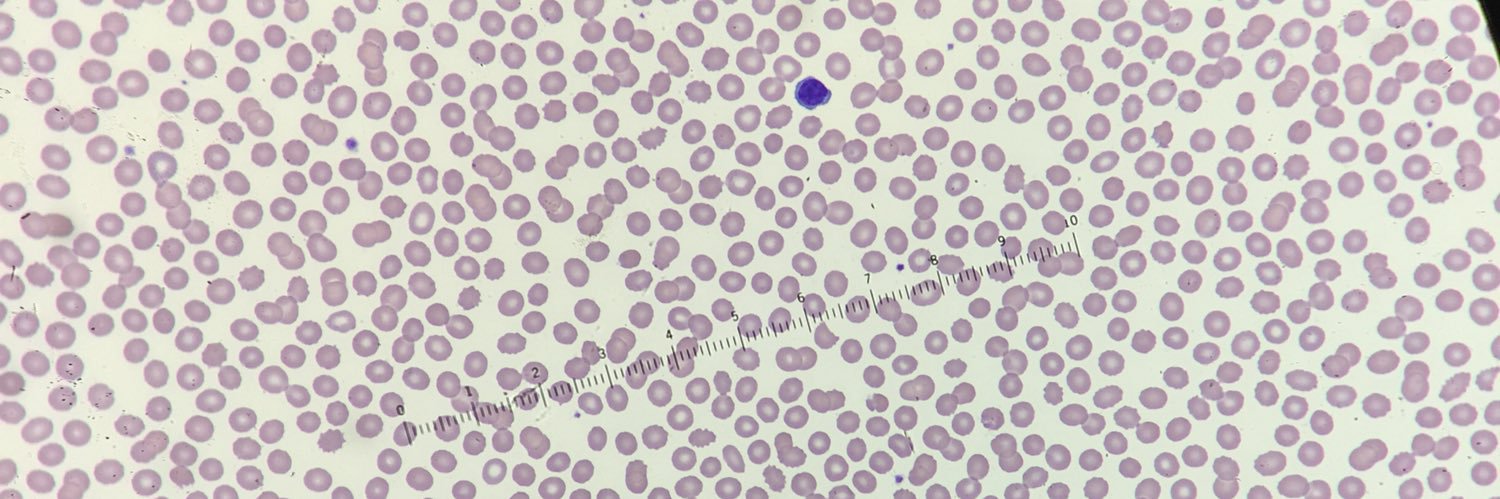
Riten Kumar, MD, MSc banner

Riten Kumar, MD, MSc retweetledi

HI-PEITHO results just out: catheter-directed #fibrinolysis superior to #anticoagulation for intermediate risk #pulmonary #embolism @Vasculearn @AnticoagForum @ThrombosisUK @ThrombosisCan @canvector @EuropeanTHA @thrombosisday @escardio @PERTConsortium

English